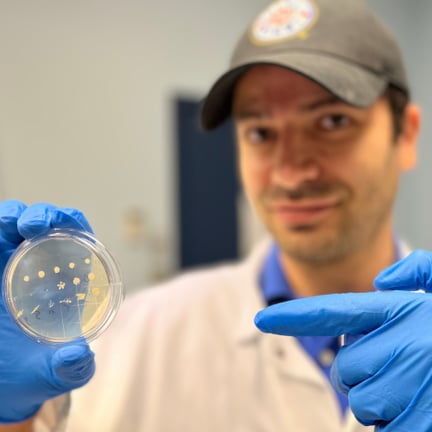
gea_3

Mitacs Accelerate Global Excellence Award
Powering Innovation Through Global Talent
Calling all exceptional international researchers and Canadians studying abroad: this is your opportunity to take part in high-impact industrial research collaborations with leading Canadian academic and industry partners.
The Mitacs Accelerate Global Excellence Award aims to draw outstanding international researcher talent and Canadians currently studying abroad to industrial research projects in partnership with leading Canadian researchers — enabled by a competitive funding package of Can$170,000 over two years.
The application deadline has been extended until September 11, 2026.

Mitacs Accelerate Global Excellence Award
Powering Innovation Through Global Talent
Calling all exceptional international researchers and Canadians studying abroad: this is your opportunity to take part in high-impact industrial research collaborations with leading Canadian academic and industry partners.
The Mitacs Accelerate Global Excellence Award aims to draw outstanding international researcher talent and Canadians currently studying abroad to industrial research projects in partnership with leading Canadian researchers — enabled by a competitive funding package of Can$170,000 over two years.
The application deadline has been extended until September 11, 2026.

About the award
The Mitacs Accelerate Global Excellence Award is an exciting funding opportunity targeting individuals who will relocate to Canada for a collaborative, industrial-based research project at an eligible Canadian academic institution and with a Mitacs-eligible partner (private company, not-for-profit organization, municipality, or hospital).
Jointly funded by Mitacs and industry partners, this award ensures strong collaboration and impact and will provide an enhanced funding package to support the costs of research as well as relocation.
Each two-year project will be valued at $170,000, broken down as follows:
- $85,000 annual award, with $42,500 + tax per year provided by the partner organization (full contribution for the first year will be invoiced upon project approval)
- Minimum of $70,000 allocated to stipend and up to $15,000 available for research and relocation expenses
Mitacs is pleased to partner with CIFAR to offer up to an additional 10 fellowships to researchers affiliated with CIFAR.
Apply for this opportunity today
Projects are collaborations between a postdoctoral fellow, a partner organization, and an academic supervisor. Eligibility is aligned to Mitacs’ Accelerate program; see "Who should apply" below for more details.
Mitacs is extending the deadline to apply for the Global Excellence Award, giving applicants another opportunity to submit proposals for consideration until September 11, 2026.
This extended opportunity will provide additional time and increased flexibility for applicants to develop strong, competitive proposals and secure the necessary project details, including allowance for submissions with unnamed postdocs. Eligibility updates were undertaken with a view to better supporting our partners in advancing high-quality international research collaborations.
All submissions received between May 2 and September 11, 2026, will be adjudicated following the September 11, 2026, closing date.
Who should apply

Postdoctoral fellows
- Must currently reside outside Canada and intend to relocate to Canada to take up the award
- Eligible within five years of PhD completion (extensions available for parental leave, military service, etc.)
- Must be eligible for postdoctoral fellow status at a Canadian institution
- Canadians/permanent residents returning to Canada or international candidates requiring a work permit are eligible
- Must not have been employed full-time at the partner organization before applying
- Must be 18 years or older

Partner organizations
- Canadian for-profit companies (must receive more than 50 percent of their funds from non-government sources); eligible not-for-profit corporations, municipalities, or hospitals in Canada
- Eligibility can be confirmed with a Mitacs Advisor

Academic supervisors
- Must be faculty at a Canadian academic institution
- Must be eligible to hold Tri-Agency funds

All parties must declare any potential conflicts of interest upon application submission, including:
An academic supervisor in a position of ownership, employment or influence over operations at the partner organization
A postdoctoral fellow in a position of ownership, employment or influence over operations at the partner organization
Program participants with a close family relationship with each other, or with someone in a position of ownership, employment or influence at the partner organization
Frequently asked questions
Can an academic supervisor and partner organization apply without the postdoctoral intern identified?
Yes. The postdoc is not required to be named at the time of application.
Can multinational companies participate as the partner organization?
Given the specific objectives of the initiative, partner eligibility is targeted at domestic Canadian companies. Canadian arms of large multinationals may apply, but will be encouraged to focus on domestic benefits and retention of top talent in Canada.
Are Canadian citizens eligible to participate as interns?
This call is to attract Canadian or foreign citizens who are currently residing outside of Canada.
I’m a postdoc in Canada / I have a postdoc that I want to appoint to the project who is currently in Canada. Why can’t they participate as an intern?
This call is to incentivize top international postdoctoral fellows to choose Canada as a research destination by offering a competitive funding package to support relocation and opportunities with Canadian industry partners. In doing so, the award strengthens the Canadian economy by bringing leading researchers to study domestically while providing pathways for long-term talent retention in key fields.
Does the intern need to be an active postdoc outside Canada or could they be a final-year PhD student looking for postdoctoral opportunities?
PhD students who are graduating soon and looking for postdoctoral positions may apply. If selected, they must hold postdoctoral status at an eligible Canadian institution for the duration of the award.
When would be the latest start date possible for Accelerate Global Excellence?
Interns must begin their project within 1 year of project approval. If the intern cannot begin the project within 1 year of project approval, please reach out to accelerate@mitacs.ca regarding an exception request.
Will revisions be allowed?
As this is a competitive call, there will be no opportunity for revisions. Applications that are unsuccessful in the competitive call may be offered the opportunity to revise and resubmit for standard Accelerate PDF funding (currently $60K per year).
Can applicants submit an application with multiple interns? Can the Global Excellence Fellowship be part of/embedded within a larger application?
No.
If I had a recently approved project for a PDF, can it be considered retroactively for this funding opportunity?
No.
Will exception requests be considered for PDFs who are more than 5 years beyond their PhD?
As for standard Accelerate, extensions to the 5-year rule are available for parental or medical leave, military service, etc.
What if an intern leaves part way through the project? Will an intern replacement be allowed?
This will be dealt with on a case-by-case basis. An exception request should be sent through the usual process.
What if someone comes to Canada from abroad before the call opens or during the call period in hopes of being a successful applicant?
Eligibility is based on the applicant’s current or most recent university or employment affiliation, which must be outside of Canada.
- Individuals who are currently affiliated with, or recently graduated from, an institution outside of Canada and intend to relocate to Canada are eligible to apply.
- Individuals who are already affiliated with a Canadian institution when the call opens are not eligible to apply for the Global Excellence Award but are able to apply to our standard Accelerate Award.
- Canadian citizens who have already returned to Canada prior to applying for a GEA are not eligible.
Does receiving an award fast-track my immigration application?
Unfortunately, no. Receiving an award does not expedite the immigration process. You must still apply for the appropriate study or work visa through the standard application procedures.
How can I apply to the Global Excellence Award as a CIFAR fellow?
CIFAR and Mitacs will co-brand up to 10 awards from applicants affiliated with CIFAR. Please note that CIFAR cannot be the partner in the Global Excellence Award application. The academic supervisor from the CIFAR network must still find an eligible project with a partner organization that will contribute financially to the project. The applicants associated with CIFAR are asked to add “CIFAR” at the beginning of the title of their project so that we can easily identify them. For more information on this partnership: Mitacs Launches Acclerate Global Excellence Award
Global talent in action
Mitacs' talent-first model includes support and opportunities for highly skilled international postdoctoral researchers who bring fresh perspectives and practical solutions to real-world challenges. Many Mitacs postdocs have transformed their research into commercial impact. These are just a few examples.

Applying research to meet mobility needs
Vancouver-based Human In Motion Robotics provides a mobility solution for people with lower extremity motor deficits and severe mobility impairments. The company's XoMotion™ exoskeleton allows users to walk and stand with natural movements, training the body to recover movement when possible.
It’s an ambitious, cross-disciplinary project that Nafise Faridi Rad is proud to be part of as a postdoctoral fellow. A PhD graduate from the University of British Columbia, Rad began studying robotics with the ambition to see her work move beyond the lab and into commercial applications.
Through her Mitacs Accelerate postdoc with Human In Motion Robotics, Nafise has gained hands-on experience applying her research in real-world settings, with interdisciplinary collaboration helping to identify challenges and bring practical solutions closer to market.

Building better batteries for global markets
As a postdoctoral fellow at Dalhousie University, Ravindra Kempaiah studied the development and commercialization of long-lifetime lithium-ion batteries for light electric vehicles. By working with Dalhousie’s Dr. Jeff Dhan — a pioneering developer of the lithium-ion battery technology used today — Kempaiah propelled his academic expertise and experience to launch a company.
With support from the Mitacs Accelerate Entrepreneur program, Kempaiah founded Zen Energy in 2021. The Dartmouth, Nova Scotia-based company innovates and commercializes long-lifetime batteries for electric vehicles and energy storage systems. Kempaiah is now developing digital AI twins that can track battery performance to improve design, adaptability, and reliability.
The technology is being developed within Canada but applied to global solutions to meet the growing market for battery-powered vehicles.
From lab to CEO with Mitacs’ support
As a PhD student conducting research at Children’s Hospital, Ali Pormohammad saw firsthand the need for the development of new biotech and medicines. “I was doing an internship and seeing lots of kids and patients dying due to infections for which we used to have treatment," he says. "Available antibiotics are getting resistance and it’s challenging both diagnosis and treatment in the infection field."
Pormohammad had worked on antimicrobial resistance (AMR) for over a decade when he joined a leading lab in biological sciences while a postdoctoral fellow at the University of Calgary. Despite initial obstacles in finding industry partners to tackle AMR, Pormohammad connected with one within a week of joining the Mitacs Elevate program.
Pormohammad later joined the Accelerate Entrepreneur program and went on to become the founder of MHCombiotic in Alberta, helping advance patented solutions to AMR.
Start your own success story
Additional pathways
Applicants not selected for the Global Excellence award may be offered the Mitacs Accelerate Postdoctoral Award (Can$60,000 per year). This provides a pathway to pursue research in Canada, gain hands-on experience, and collaborate with leading industry partners.